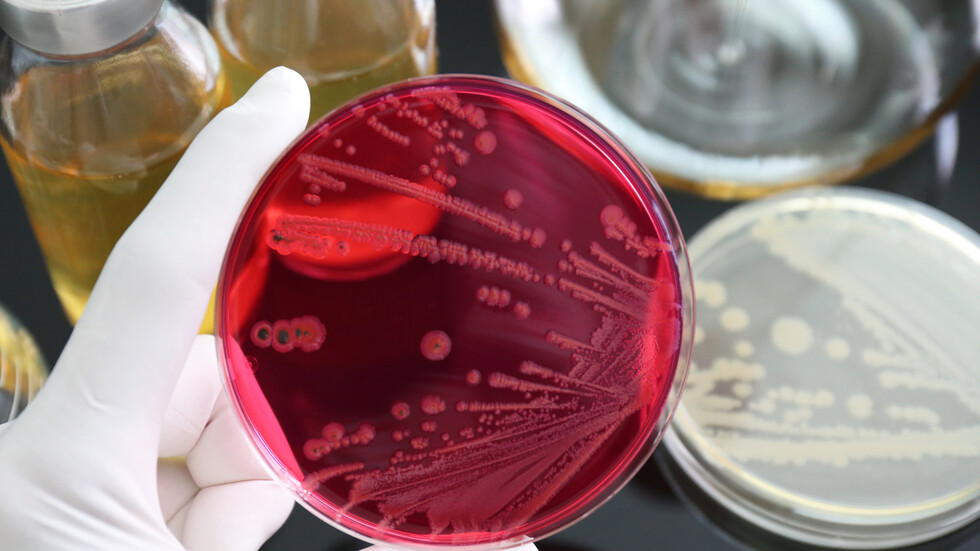

Снимка: iStock
Продуктите са били в срок на годност
Гръцкият орган за контрол на храните изтегли от пазара партида замразени пилешки филета, както и замразени свински кюфтенца, предаде гръцката национална телевизия ЕРТ. Причината е, че по време на проверки е открито наличието на бактерията салмонела.
Заради грешка на лаборатория: Майка не подозира, че детето ѝ е болно от салмонелоза
Номерът на партидата със замразено свинско месо е 202314511 и е със срок на годност до 14 септември. Замразените пилешки филета са в опаковки от един килограм с номер 13062023 и срок на годност до юни.
От гръцкия орган призоваха потребителите, които са закупили тези продукти, да не ги консумират.
14 души са със салмонела след посещение на ресторант в "Св. св. Константин и Елена"
Редактор: Габриела ПавловаПоследвайте ни















































